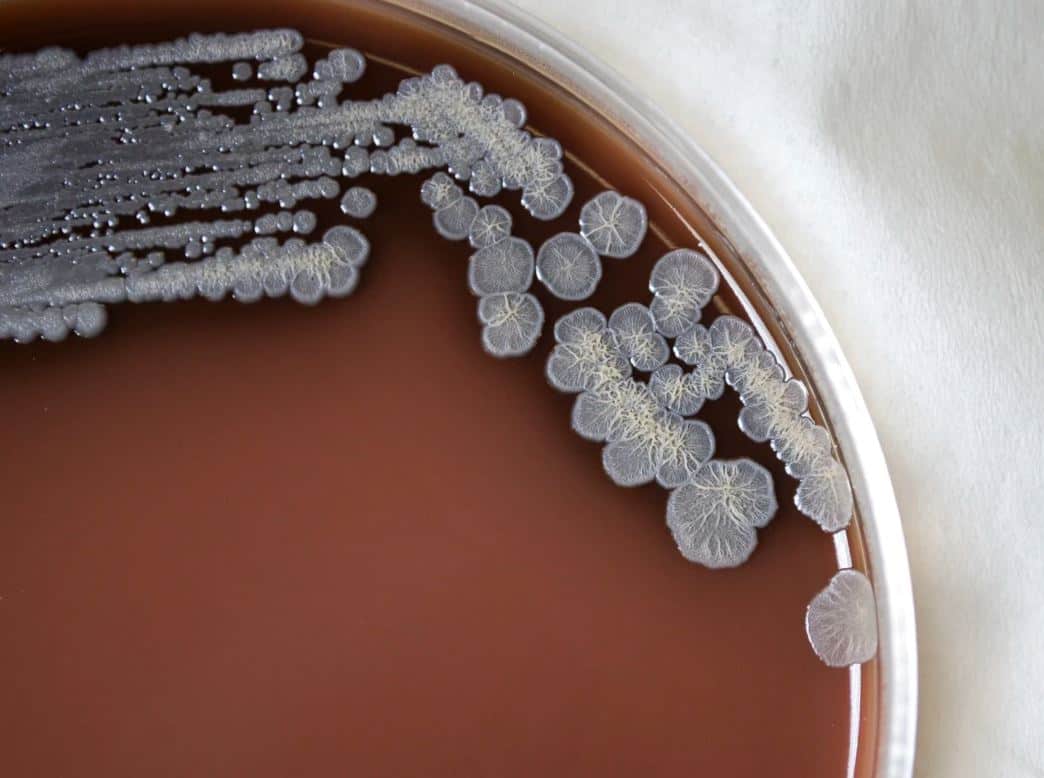
Une bact&eacute;rie causant une grave maladie infectieuse d&eacute;tect&eacute;e aux &Eacute;tats-Unis

Une bactérie causant une grave maladie infectieuse détectée aux États-Unis
TVA Nouvelles
Les autorités sanitaires américaines ont annoncé mercredi que des échantillons de terre et d'eau prélevés dans le Mississippi contenaient une bactérie causant une rare, mais grave maladie appelée mélioïdose.
• À lire aussi: Réduisez vos partenaires sexuels conseille l'OMS
• À lire aussi: Variants BA.4 et BA.5 : méfiez-vous de votre test négatif
• À lire aussi: La ville de New York demande de rebaptiser la variole du singe, un nom jugé stigmatisant
Les autorités ont ainsi alerté les médecins du pays, leur demandant d'être vigilants face à de possibles symptômes de cette maladie chez des patients.
Deux individus vivant dans le sud des États-Unis, dans la région du golfe du Mexique, ont séparément contracté la maladie en 2020 et 2022, poussant les Centres de prévention et de lutte contre les maladies (CDC) à réaliser ces prélèvements dans et près de leurs maisons.
Trois échantillons, de terre et de flaques d'eau, se sont révélés positifs à la bactérie (Burkholderia pseudomallei).
Malgré tout, les CDC considèrent que le risque pour la population générale reste «très faible». Ils enquêtent actuellement pour déterminer à quel point la bactérie est répandue dans l'environnement.
Les symptômes de la mélioïdose peuvent être larges, comme de la fièvre, des douleurs aux articulations, ou des maux de tête. Elle peut causer des pneumonies, la formation d'abcès, ou des infections. Dans le monde, la mélioïdose est mortelle dans 10 à 50% des cas.

Événements de Formule 1 annulés: «Je crois que la décision est la bonne», affirme François Dumontier
La guerre au Moyen-Orient a eu des conséquences sur le calendrier de la Formule 1 qui a vu les événements au Bahreïn et en Arabie saoudite être annulés. Un choix inévitable compte tenu des enjeux de sécurité, selon un ancien directeur des opérations du Grand Prix du Canada.












